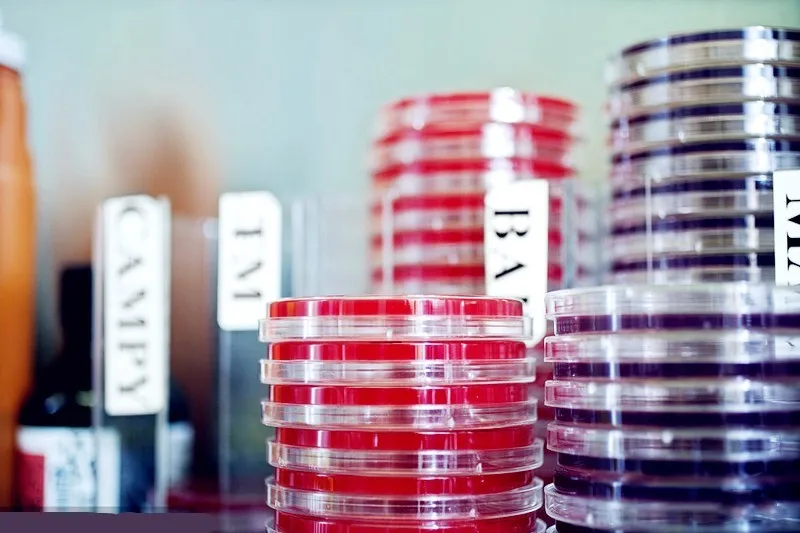

Share on (1600624655030):

Specification | AMD280 | AMD110 | |
Basic device (L×W×H) | 60×61×38cm | ||
With carrousel (H) | 99 cm | 65 cm | |
Carrousel (H) | 56 cm | 23 cm | |
Max.loading petri dishes | 241 pcs | 101 pcs | |
Basic device (Weight) | 44 kg | ||
Carrousel (Weight) | 9 kg | 6.5 kg | |
Input voltage | 220V/110V±10%, 50/60Hz | ||
Electricity consumption | 260 W | ||
Filling range / Dispense precision | 1-99ml / 1% | ||
Filling range of manual dispense | 1-999 ml | ||
Flow rate setting | 600ml/min, 1000ml/min | ||
Petri dish type | 90mm (standard), 100mm, 60mm, accept custom-made | ||
Dispense speed | 500 dishes/hour (volume:20ml) | ||
Dispense precision | 1% | ||








New products from manufacturers at wholesale prices